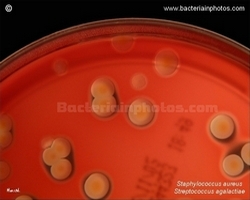
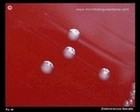
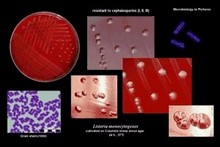
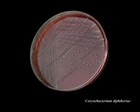
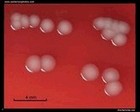
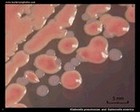
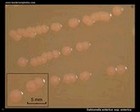
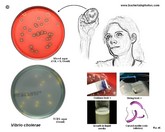

GRAM-POSITIVE BACTERIA
|
GRAM-NEGATIVE BACTERIA
| COCCI | RODS ACID FAST BACTERIA | COCCI SPIROCHETES SPIRILLI | RODS |
|
|
GRAM-POSITIVE BACTERIA |
GRAM-POSITIVE COCCI | |
 | | Staphylococcus |  | | Gram stain: | Gram-positive | | Microscopic appearance: | cocci in grape-like clusters | | Oxygen relationship: | facultatively anaerobic bacteria |
| Motility: | nonmotile | | Catalase test: | catalase-positive | | Oxidase test: | negative* | | Spores: | non-spore forming | | | * Some species (non-human isolates) are positive |
|
Staphylococcus aureus | - Beta-hemolysis on media with blood (sheep, horse)
- Yellow-pigmented colonies
- NaCl tolerant (7.5%), mannitol fermentation
- Production of coagulase (free and cell-bound coagulase)
- Lithium chloride and potassium tellurite tolerant
- Lecithinase production and lipase activity
| |
|
 |
| Beta-hemolysis on media with blood |
|
 Beta hemolysis Staphylococcus aureus |
 Staphylococcus aureus Beta hemolysis on blood agar |  Staphylococcus aureus Beta hemolysis on blood agar |  Staphylococcus aureus Colonies on blood agar |
Staphylococcus aureus Beta hemolysis, weak pigmentation |
Colonies of Staphylococcus aureus are usually yellow-pigmented and beta-hemolytic (but not always!) |
 Staphylococcus aureus non-pigmented colonies weak hemolysis |  Staph. aureus non-pigmented strain |
 S.aureus two shades of yellow... |  Staphylococcus aureus staphyloxanthin |
| Yellow colonies (staphyloxanthin) |
 Staphylococcus aureus yellow colonies on TSA |
 Staphylococcus aureus on Brain Heart Infusion Agar |  Staphylococcus aureus on Tryptic Soy Agar |  Staphylococcus aureus Chocolate Agar |
 Staphylococcus aureus on Schaedler Agar |
 Staphylococcus aureus Beta-hemolytic colonies |  Staphylococcus aureus on Tryptic Soy Agar |
 Staphylococcus aureus and Staphylococcus epidermidis on Chocolate Agar |  Catalase test
|
 Staphylococcus aureus on Baird Parker Agar |
Staphylococcus aureus and S.epidermidis Baird Parker Agar |  Colonies of S.aureus lecithinase +, lipase + |  Staphylococcus aureus and S.epidermidis Mannitol Salt Agar |
Staphylococcus aureus Mannitol Salt Agar Mannitol + |
Methicilin Resistant S.aureus MRSA | |
 MRSA Staphylococcus aureus on Brilliance MRSA Chromogenic Agar |  Staphylococcus aureus ORSAB |
The disc diffusion testing |  S.aureus and E.faecalis on CAP agar |  S.aureus colony |
Clumping factor (Bound coagulase) | Decapsulation test | Biofilm formation | Susceptibility to antibiotics | S.aureus and penicillin (it saved millions...) 80,000,000?? 200,000,000?? |
 Bound coagulase (clumping factor) |  Hyaluronidase |  Staphylococcus aureus biofilm formation |  The disc diffusion testing |
 Staphylococcus aureus and discovery of penicillin |
| Images of Staphylococcus aureus |
 |
 |
 |
 |
 |
 |
|
 |
 |
 |
 |
 |
 |
 |
 |
 |
|
|
|
Antibiotic Treatment Should be always guided by in vitro susceptibility tests! Selection of appropriate antibiotics depends on diagnosis! | | IF SUSCEPTIBLE: Treatment of Methicillin Sensitive Staphylococcus aureus (MSSA) | | Penicillins | Cephalosporins | Lincosamides | Alternatives | | | | | Treatment of Methicillin-Rresistant Staphylococcus aureus (MRSA) | | Glycopeptides |
Sulfonamides | Lipopeptides | Oxazolidonones | | | | |
| Tetracyclines | Lincosamides | Streptogramins | Rifamycins | | | | |  | Useful links |
|
Staphylococcus epidermidis | - Gamma-hemolysis on media with blood (sheep, horse)
- White colonies
- NaCl tolerant (7.5%), doesn't ferment mannitol
- Coagulase negative
- Lecithinase, lipase negative
| |
|
 Staphylococcus epidermidis on Tryptic Soy Agar
|
 Staphylococcus epidermidis
|  Staphylococcus epidermidis on blood agar |  Staphylococcus epidermidis colonies on blood agar |
 Staphylococcus epidermidis on CAP agar |
 Staphylococcus epidermidis and Staphylococcus aureus
|  S.epidermidis, S.aureus, E.faecalis on Tryptic Soy Agar |
 Staphylococcus epidermidis on Tryptic Soy Agar
| | |
|
Staphylococcus sp. micrographs |
 Staphylococcus aureus and Klebsiella pneumoniae (Gram stain) |
 Staphylococcus aureus micrograph (Gram stain) |  Staphylococcus aureus Gram stain |  Staphylococcus aureus Ziehl-Neelsen stain |
 Staphylococcus aureus SEM micrograph |
 Staphylococcus aureus SEM |  Staphylococcus aureus SEM micrograph |
Staphylococcus aureus MRSA |  MRSA micrograph methicillin-resistant Staphylococcus aureus |  |
| Three-dimensional (3D) computer-generated images |
 Image of MRSA
|  Staphylococcus MRSA |
 Vancomycin-resistant Staphylococcus aureus |
 | | Streptococcus | | | Gram stain: | Gram-positive | | Microscopic appearance: | cocci in chains (liquid media) or pairs | |
Oxygen relationship: | facultatively anaerobic bacteria | | Motility: | nonmotile | | Catalase test: | catalase-negative | | Oxidase test: | negative | | Spores: | non-spore forming | | | |
|
ALPHA-HEMOLYTIC STREPTOCOCCI VIRIDANS STREPTOCOCCI
- Mitis Group: e.g. S.mitis, S.oralis, S.sanguis (part of the normal dental plaque flora)
- Anginosus Group: e.g.S.anginosus, S.constellatus, S.intermedius (oral, genitourinary flora, gastrointestinal tract); can be beta-hemolytic
- Mutans Group: e.g.S.mutans (associated with dental caries); some strains can be beta-hemolytic
- Salivarius Group: e.g.S.salivarius, S.vestibularis (oral cavity)
- Bovis Group: e.g.S.bovis
- Clinical significance: some of them can be the causative agents of subacute endocarditis, abscesses and infections in neutropenic patients
| |
Alpha and gamma hemolysis |
Alpha-hemolytic streptococci throat swab |
 Viridans streptococci |
Viridans streptococci |
Streptococcus spp. viridans streptococci optochin resistant |
 Streptococcus anginosus on BAP |
 Streptococcus mitis blood culture |
 Streptococcus mutans |
 Viridans streptococci blood culture specimen |
Antibiotic Treatment Should be always guided by in vitro susceptibility tests! Selection of appropriate antibiotics depends on diagnosis! | | Endocarditis |
| Penicillins | Cephalosporins | Glycopeptides | Alternatives | |
|
| | | |
|
PNEUMOCOCCUS
- Oropharyngeal carriage of pneumococci is common
- An important agent of community-acquired pneumonia
- Otitis media, sinusitis, meningitis, endocarditis
- Require elevated CO2 concentrations (incubation in an atmosphere containing 5% - 10% CO2)
- Sensitive to optochin
- Soluble in bile salts
- Positive Quellung test
|
 |
|
Streptococcus pneumoniae on blood agar |
 Streptococcus pneumoniae depressed centers of colonies |
 Streptococcus pneumoniae virulent strain |
Streptococcus pneumoniae alpha-hemolysis under colonies |
 Streptococcus pneumoniae avirulent strain |
Streptococcus pneumoniae optochin test Comparision of virulent and avirulent strain |
Streptococcus pneumoniae bile solubility test |
Streptococcus pneumoniae in sputum (micrograph) |
 Streptococcus pneumoniae in cerebral spinal fluid |  |
 Streptococcus pneumoniae on Petri dish virulent strain |
 Streptococcus pneumoniae on blood agar virulent strain |
 Streptococcus pneumoniae virulent and avirulent strain |
 Streptococcus pneumoniae avirulent strain and viridans streptococci |
 Streptococcus pneumoniae 3D model |
|
Antibiotic Treatment Should be always guided by in vitro susceptibility tests! Selection of appropriate antibiotics depends on diagnosis! | | Penicillin sensitive Streptococcus pneumoniae | | Penicillins | Cephalosporins | Macrolides | Alternatives | | | | | | Penicillin resistant Streptococcus pneumoniae | | Cephalosporins | Glycopeptides | Alternatives | | |
| | |
|
|
- Group A Lancefield antigen
- PYRase positive
- bacitracin susceptible
|  |
 Beta and gamma hemolysis (GAS = Group A Strep.) |
.jpg) Beta and gamma hemolysis |  Streptococcus pyogenes on blood agar large colonies |  Streptococcus pyogenes PYRase positive |
 Beta hemolysis on sheep blood agar (S.pyogenes) |
 Streptococcus pyogenes beta hemolysis |  Colonies of Streptococcus pyogenes |
 Colonies of S.pyogenes on blood agar |  Beta hemolysis Beta-hemolytic colonies of S.pyogenes |  PYRase (PYR test) |
 Sensitive to penicillin
|
 Latex agglutination
|  Group A Streptococcus latex agglutination |  Streptococcus pyogenes 3D computer-generated image |  Strep throat |
|
|
Antibiotic Treatment Should be always guided by in vitro susceptibility tests! Selection of appropriate antibiotics depends on diagnosis! | | | | Penicillins | Cephalosporins | Macrolides (patients allergic to penicillin) | Alternatives | |
- Peroral cephalosporins (I, II)
| | | |
| |
|
- Group B Lancefield antigen
- CAMP test positive
- hydrolyze sodium hippurate
- Often weaker (partial) beta-hemolysis
|
 |
 |
 Streptococcus agalactiae
|
Streptococcus agalactiae
|  Streptococcus agalactiae on blood agar |  Positive CAMP test |  CAMP test and reverse CAMP test |
 CAMP test detail |  CAMP test on Petri dish |  Latex agglutination of GBS
|  Biochemical identification of S.agalactiae |  Streptococcus agalactiae 3D model |
|
Antibiotic Treatment Should be always guided by in vitro susceptibility tests! Selection of appropriate antibiotics depends on diagnosis! | | | | Penicillins | Cephalosporins | Macrolides (patients allergic to penicillin) | Alternatives | |
- Peroral cephalosporins (I, II)
| | | | | |
BETA-HEMOLYTIC STREPTOCOCCI OF GROUP C |
 Streptococcus equi ssp. equi on Petri dish |
 Streptococcus equi ssp. equi colonies on blood agar |  Streptococcus zooepidemicus on blood agar |  Streptococcus equi ssp. equi on blood agar |  Streptococcus zooepidemicus on tryptic soy agar |
 Streptococcus zooepidemicus on brain heart agar |
Streptococcus sp. micrographs |
 Streptococcus agalactiae micrograph |  Streptococcus sp.
|
 Streptococcus pyogenes Gram stain |  Streptococcus sp. Group C
|  Streptococcus sp.
|
BETA-HEMOLYTIC STREPTOCOCCI OF GROUP F and G |
| |
|
Many of the images below are not working yet. How quickly and if and when we finish the rest depends on you. Please give us a link from your website. Your decision will determine if it's worth to continue and how this part of the internet will look tomorrow. |
 | | Enterococcus |
 | | Gram stain: | Gram-positive | | Microscopic appearance: | cocci or ovoid cocci in pairs, clusters or short chains (liquid media) | | Oxygen relationship: | facultatively anaerobic bacteria | | Motility: | nonmotile or motile | | Catalase test: | catalase-negative
| | Oxidase test: |
negative | | Spores: | non-spore forming | | | |
|
 Enterococcus faecalis |  Enterococcus faecalis |  Enterococcus faecalis |  Enterococcus faecalis |
 Enterococcus
|
 Enterococcus faecalis |  Enterococcus faecium
|  Enterococcus faecalis |  Enterococcus faecalis and Staphylococcus aureus
|
Enterococcus faecalis
|
Enterococcus faecalis |  Enterococcus faecalis |  Enterococcus faecalis on blood agar |  Enterococcus faecium
|
 Enterococcus
|
 Enterococcus faecalis Gram stain |  Enterococcus faecalis scanning electron micrograph (SEM) |
| Useful links |
GRAM-POSITIVE BACILLI (RODS) | |
 | | Listeria | | | Gram stain: | Gram-positive | | Microscopic appearance: | short rods (sometimes coccoid forms), single or in chains | | Oxygen relationship: |
facultatively anaerobic bacteria | | Motility: | motile (at 20-25°C)*; peritrichous flagella | | Catalase test: | catalase-positive | | Oxidase test: | negative | | Spores: | non-spore forming | | | * optimal growth temperature at 30-37°C | | Listeria monocytogenes is the causative agent of listeriosis |
|
 |
 Listeria monocytogenes on blood agar |
 Listeria monocytogenes on blood agar |
 Listeria monocytogenes on blood agar |
 Listeria monocytogenes on blood agar |
 Listeria monocytogenes
|
 Listeria monocytogenes beta hemolysis |
 Listeria monocytogenes CAMP test |
 Listeria monocytogenes colonies on blood agar |
 Listeria monocytogenes on blood agar |
 Listeria monocytogenes PALCAM agar |
 Listeria monocytogenes ampicillin susceptibility |
 Listeria monocytogenes susceptibility to antibiotics |
 Listeria monocytogenes susceptibility to cephalosporins |
 Listeria monocytogenes Gram-stain |
 Listeria monocytogenes microscopy |
 Listeria monocytogenes |
| Useful links |
 | |
Corynebacterium |  | | Gram stain: | Gram-positive | | Microscopic appearance: | rods, often broader at one end ("club" shape), grouped together in a characteristic way ("V", "palisades", "Chinese letters") | | Oxygen relationship: | facultatively anaerobic bacteria | |
Motility: | nonmotile | | Catalase test: | catalase-positive | | Oxidase test: | negative | | Spores: | non-spore forming* | | | *metachromatic granules are often present. | | Corynebacterium diphtheriae is the causative agent of diphtheria |
|
 |
 Corynebacterium diphtheriae
| Corynebacterium diphtheriae
|  Corynebacterium diphtheriae
|
 Corynebacterium diphtheriae Gram stain |  C.pseudotuberculosis on blood agar |
| Useful links |
 | |
Bacillus | | | Gram stain: | Gram-positive | | Microscopic appearance: | rods in chains | | Oxygen relationship: | aerobic or facultatively anaerobic bacteria | | Motility: | motile (peritrichous flagella) or nonmotile (e.g., B.anthracis) | | Catalase test: | catalase-positive | | Oxidase test: |
negative | | Spores: | spore forming (endospores) | | | | | Bacillus anthracis is the causative agent of anthrax |
|
 |
 Bacillus cereus |
 Bacillus cereus on blood agar |  Bacillus subtilis |  Bacillus subtilis |  Bacillus subtilis |
 Bacillus anthracis causative agent of anthrax |
 Bacillus anthracis
|  Bacillus anthracis on blood agar |  Bacillus anthracis colonies on blood agar |
 Bacillus anthracis capsule production |
 Bacillus anthracis
|  Bacillus sp. colonies on Mueller-Hinton agar |
Bacillus mycoides
|  Bacillus mycoides growth on agar |
 Serratia marcescens and Bacillus mycoides |  Bacillus mycoides Gram stain |
 Gram-positive sporulating bacterium
|  Bacillus anthracis micrograph
|  Escherichia coli and Bacillus sp. Gram stain |
| Useful links
|
|
 | | Lactobacillus | | | Gram stain: | Gram-positive | | Microscopic appearance: | rods in chains or palisades | | Oxygen relationship: | facultatively anaerobic or anaerobic bacteria | | Motility: | nonmotile (most of them) |
| Catalase test: | negative | | Oxidase test: | negative | | Spores: | non-spore forming | | | |
|

| 
| 
|
| |
| Useful links |
 | | Streptomyces |  | | Gram stain: | Gram-positive | | Microscopic appearance: | rods; form substrate and aerial mycelium | | Oxygen relationship: |
aerobic bacteria | | Motility: | nonmotile | | Catalase test: | positive | | Oxidase test: | negative | | Spores: | spore forming (aerial mycelium) | | | |
|
 Streptomyces spp. |
Streptomyces spp.
|  Streptomyces coelicolor on Mueller-Hinton agar | .jpg) Streptomyces coelicolor colony on Mueller-Hinton agar |  Streptomyces sp. on agar plate |
 Streptomyces sp. |  Streptomyces sp. |  Streptomyces sp. |  Streptomyces sp. |  Streptomyces sp. |
| Useful links |
 | | Clostridium | | | Gram stain: | Gram-positive (young cultures), often Gram-variable | | Microscopic appearance: | rods (in pairs or chains) | | Oxygen relationship: | anaerobic bacteria | | Motility: | usually motile (peritrichous flagella) | | Catalase test: |
negative | | Oxidase test: | negative | | Spores: | spore forming (endospores) | | | |
|
 |
 Clostridium sordellii |  Clostridium sordellii colonies |
 Clostridium perfringens |  Clostridium perfringens |  Clostridium perfringens |
 Clostridium sordellii micrograph |  Clostridium ramosum |
| Useful links |
GRAM-NEGATIVE BACTERIA |
GRAM-NEGATIVE COCCI | |
 | | Neisseria |  | | Gram stain: | Gram-negative | | Microscopic appearance: |
diplococci, cocci | | Oxygen relationship: | aerobic bacteria | | Motility: | nonmotile
| | Catalase test: | positive | | Oxidase test: | positive | | Spores: | non-spore forming | | | |
|
Neisseria meningitidis - growth on blood agar
- CO2 enhances growth, but is not required
- acid production from glucose and maltose
| | Neisseria gonorrhoeae - fastidious in its growth requirements
- special media for cultivation
- most strains require an atmosphere containing CO2
- colonies are well developed after 48 hr.
- four colony types have been recognized (T1-T4)
- acid production from glucose (maltose negat.)
|
 Colonies of Neisseria meningitidis |  Neisseria meningitidis on New York City Agar | |  Neisseria gonorrhoeae |
 Neisseria gonorrhoeae on New York City Agar |
 Colonies of Neisseria meningitidis Oxidase test + |
Neisseria meningitidis Biochemical identification | |  Neisseria gonorrhoeae
|  Neisseria gonorrhoeae |
 Neisseria meningitidis micrograph |
Neisseria meningitidis Oxidase test | |  Neisseria gonorrhoeae |
 | | Moraxella (Branhamella) |  | | Gram stain: | Gram-negative |
| Microscopic appearance: | diplococci, cocci, cocobacilli | | Oxygen relationship: | aerobic bacteria* | | Motility: | nonmotile
| | Catalase test: | positive | | Oxidase test: | positive | | Spores: | non-spore forming | | | * some facultatively anaerobic |
|
Moraxella catarrhalis
|  Moraxella catarrhalis on blood agar |  Moraxella catarrhalis on blood agar |  Moraxella catarrhalis
|  Moraxella catarrhalis Gram stain |
| Useful links |
 | | Bordetella |  | | Gram stain: | Gram-negative | | Microscopic appearance: | small rods or cocobacilli | | Oxygen relationship: | aerobic bacteria |
| Motility: | nonmotile or motile
| | Catalase test: | positive | | Oxidase test: | positive | | Spores: | non-spore forming | | | |
|
 |
 Bordetella pertussis on charcoal agar |
 Bordetella pertussis on charcoal agar |  Bordetella pertussis
|
 | | Haemophilus |
 | | Gram stain: | Gram-negative | | Microscopic appearance: | small pleomorphic rods | | Oxygen relationship: | facultatively anaerobic bacteria | | Motility: | nonmotile
| | Catalase test: | variable | | Oxidase test: | variable | |
Spores: | non-spore forming | | | |
|
 |
 Haemophilus influenzae on chocolate agar |  Haemophilus influenzae on chocolate agar |
 Haemophilus influenzae on chocolate agar |  Haemophilus influenzae on blood agar Satellite test |  Haemophilus influenzae Satellite test |
 Haemophilus influenzae X + V factor |  Haemophilus influenzae micrograph Pleomorphic G- bacilli |
 | |
Pseudomonas | | | Gram stain: | Gram-negative | | Microscopic appearance: | rods | | Oxygen relationship: | aerobic bacteria | | Motility: | motile (rarely nonmotile)
| | Catalase test: | positive | | Oxidase test: | positive or negative | | Spores: |
non-spore forming | | | |
|
 Pseudomonas aeruginosa on Tryptic Soy Agar |  Pseudomonas aeruginosa
|  Pseudomonas aeruginosa
|  Pseudomonas aeruginosa on blood agar |
 Colony of Pseudomonas aeruginosa and Staphylococcus aureus |
 Pseudomonas aeruginosa and Enterococcus faecalis |  Pseudomonas aeruginosa on Tryptic Soy Agar |
 Pseudomonas aeruginosa on Tryptic Soy Agar |  Pseudomonas aeruginosa, Staphylococcus aureus, Enterococcus faecalis |  Pseudomonas aeruginosa and Staphylococcus aureus on TSA |
 Pseudomonas aeruginosa
|  Pseudomonas aeruginosa colonies on blood agar |  Pseudomonas aeruginosa on cetrimide agar |
Pseudomonas sp. |  Pseudomonas aeruginosa
|
 Staphylococcus spp. and P.aeruginosa on blood agar |  Pseudomonas aeruginosa
|
 | |
Enterobacteriaceae |  | | Gram stain: | Gram-negative | | Microscopic appearance: | rods | | Oxygen relationship: | facultatively anaerobic bacteria | | Motility: | motile (peritrichous flagella) or nonmotile | | Catalase test: |
positive | | Oxidase test: | negative (with exception of Plesiomonas spp.) | | Spores: | non-spore forming |
|
Escherichia coli |
 |
 Escherichia coli on MacConkey agar |  Escherichia coli on CLED agar |
 Escherichia coli on CLED agar |  Escherichia coli on Brain Heart Infusion Agar |  Escherichia coli on Tryptic Soy Agar |
 Escherichia coli on MacConkey agar | Escherichia coli on blood agar |
 Escherichia coli, Klebsiella pneumoniae and Salmonella enterica on blood agar |
 Escherichia coli on MacConkey agar |
 Escherichia coli on Endo agar |  Escherichia coli Gram stain |
 Escherichia coli scanning electron micrograph (SEM) |
 Escherichia coli identification |
Klebsiella pneumoniae |
 Klebsiella pneumoniae
|
Klebsiella pneumoniae on MacConkey |  Klebsiella pneumoniae on CLED |  Klebsiella pneumoniae on Endo |  Klebsiella pneumoniae on MacConkey agar |
 K.pneumoniae colonies on MacConkey
|
 Klebsiella pneumoniae on Endo agar |  Klebsiella pneumoniae on desoxycholate-citrate agar |  Klebsiella pneumoniae and Staphylococcus aureus Gram stain |
 Klebsiella pneumoniae identification |
Salmonella enterica |
 |
 Salmonella and E.coli on XLD |  Salmonella, E.coli, Klebsiella on MacConkey |  Salmonella
|  Salmonella on XLD |
 Salmonella enterica on Deoxycholate Citrate Agar |
 Salmonella enterica on blood agar | Salmonella enterica and Klebsiella pneumoniae |  Salmonella and E.coli on MacConkey |
 Salmonella enterica and E.coli on XLD | Salmonella enterica on MacConkey |
 Salmonella enterica SEM |  Salmonella enterica SEM |
 Salmonella identification |
Serratia marcescens |
Serratia marcescens CLED |  Serratia marcescens prodigiosin |  Serratia marcescens
|  Serratia marcescens MacConkey |  Serratia marcescens on ENDO and MacConkey |
Citrobacter | Enterobacter |
 Citrobacter freundii blood agar |  Citrobacter freundii |  Enterobacter sakazakii on Endo agar |
 Enterobacter cloacae Gram stain |
Proteus |
 Proteus mirabilis blood agar |  Proteus vulgaris blood agar |  Proteus mirabilis Tryptic Soy Agar |
 Proteus mirabilis blood agar |  Proteus mirabilis CLED |
 Proteus vulgaris identification |
 Providencia rettgeri on Endo agar |
 Morganella morganii on blood agar |
 | | Yersinia |  | | Gram stain: | Gram-negative | | Microscopic appearance: | rods or cocobacilli | | Oxygen relationship: | facultatively anaerobic bacteria | | Motility: |
motile or nonmotile at 30°C nonmotile at 37°C
| | Catalase test: | positive | | Oxidase test: | negative | | Spores: | non-spore forming | | | | | Yersinia pestis is the causative agent of plague |
|
 |
 Yersinia pestis on blood agar
|  Yersinia pestis on CIN agar
|  Yersinia pestis colonies on blood agar
|
Yersinia pestis colonies on blood agar
|  Yersinia pestis colonies on blood agar |
 Yersinia pestis CIN agar |
 Yersinia pestis SEM |
 Yersinia pestis
|  Plague cycles in the USA |
 Distribution of plague in the USA |
 Yersinia enterocolitica on CIN agar |
 Yersinia enterocolitica colonies on CIN agar |
 Yersinia enterocolitica colonies on MacConkey agar |
 Yersinia enterocolitica on Endo agar |
 Yersinia pestis
|
 Yersinia enterocolitica biochemical identification |
 | |
Vibrio | | | Gram stain: | Gram-negative | | Microscopic appearance: | curved rods (vibrios) or straight rods | | Oxygen relationship: | facultatively anaerobic bacteria | | Motility: | motile | | Catalase test: |
positive | | Oxidase test: | positive | | Spores: | non-spore forming |
|
 |
 Vibrio cholerae beta-hemolytic strain |
 Vibrio cholerae colonies on blood agar
|
 Vibrio cholerae colony morphology |
 Vibrio cholerae colonies |
 Vibrio cholerae positive oxidase test
|
 String test with Vibrio cholerae |
 Vibrio cholerae growth in a liquid medium
|
 Vibrio cholerae on MacConkey agar
|
 Vibrio cholerae Polymyxin B |
 Vibrio cholerae susceptibility testing
|
 Vibrio cholerae on TCBS agar |
 Vibrio cholerae colonies on TCBS agar |
 Vibrio cholerae on TCBS |
 Vibrio parahaemolyticus on TCBS agar |
 Vibrio parahaemolyticus on TCBS agar |
 Vibrio cholerae |
 Vibrio cholerae micrograph (SEM) |
 Vibrio cholerae |
 Vibrio cholerae Gram-stain |
Tests for identification |
| |
Campylobacter | | | Gram stain: | Gram-negative | | Microscopic appearance: | spirilli, sometimes coccoid bodies | | Oxygen relationship: | microaerobic (O2 concentration 3 - 15%, CO2 3 - 5%) some can grow aerobically or anaerobically | | Motility: | motile
| | Catalase test: | positive | | Oxidase test: |
positive | | Spores: | non-spore forming | | | |
|  Campylobacter jejuni |  Campylobacter jejuni scanning electron micrograph (SEM) |
 Campylobacter jejuni scanning electron micrograph (SEM) |
 | | Borrelia | | | Gram stain: | Not classified as either Gram-positive or Gram-negative (the cells stain a weak Gram-negative) | | Microscopic appearance: |
Spirochetes | | Oxygen relationship: | microaerobic | | Motility: | motile
| | Catalase test: | - | | Oxidase test: | - | | Spores: | non-spore forming | | | |
|
| Borrelia burgdorferi is the causative agent of Lyme disease |
 Borrelia burgdorferi scanning electron micrograph SEM |  Borrelia burgdorferi SEM |  Borrelia burgdorferi SEM |
 Borrelia burgdorferi: Lyme disease
|  Borrelia burgdorferi: darkfield microscopy
|
 Ticks as vectors for Borrelia burgdorferi |
Erythema migrans |
ACID-FAST BACTERIA |
 | | Mycobacterium |  | | Gram stain: | - (acid - fast) | | Microscopic appearance: | rods; sometimes cocobacilli or filaments |
| Oxygen relationship: | aerobes | | Motility: | nonmotile | | Catalase test: | positive | | Oxidase test: | negative | | Spores: | non-spore forming |
|
| Mycobacterium tuberculosis is the causative agent of Tuberculosis |
| Mycobacterium leprae is the causative agent of Leprosy |
 |
 Mycobacterium tuberculosis on Löwenstein-Jensen medium |  Mycobacterium sp. on Ogawa medium |  Mycobacterium fortuitum on blood agar |
 Mycobacterium vaccae |  Mycobacterium sp. |
 Mycobacterium sp. on M2 agar |  Mycobacterium sp. colony on M2 agar |
 Mycobacterium sp. and Staphylococcus aureus Ziehl-Neelsen stain |
OTHER BACTERIA |
 Stenotrophomonas maltophilia on Mueller-Hinton agar |
Chryseobacterium indologenes on Mueller-Hinton agar |  Erysipelothrix rhusiopathiae on Columbia horse blood agar |  Chromobacterium violaceum and Erwinia carotovora |
 |  Pasteurella multocida on blood agar |  Chryseobacterium indologenes and an actinomycete on Mueller-Hinton agar |
Micrococcus luteus on tryptic soy agar |  Aeromonas hydrophila on CLED agar |
 Mixture of bacteria on agar plate |  Bacterial colonies |
Bacteria and pigment production |  Bacterial colonies and hemolysis |  Bacteria: Light microscopy |
 Bacteria.... |  Bacteria images |
 Colonies of various bacteria |  Bacteria photos |
|
| | | PICTURE OF THE MONTH  BACTERIA 2013 DECEMBER |
DISK DIFFUSION METHOD FOR TESTING OF ANTIBIOTIC SUSCEPTIBILITY OF BACTERIA | |
 Susceptibility testing of bacteria |  The disc diffusion test |  The disc diffusion test (Serratia marcescens): antibiotic resistance |
 The disc diffusion method |
| |
| | |